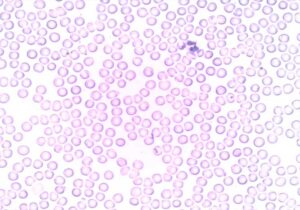

Manfaat Air Soda Selain Untuk Bahan Makanan atau Minuman
Soda adalah zat natrium karbonat yang biasanya berupa cair. Soda berasal dari air biasa yang sudah melewati proses karbonasi atau proses pencampuran karbon dioksida dalam minuman dengan tekanan tinggi. Soda…